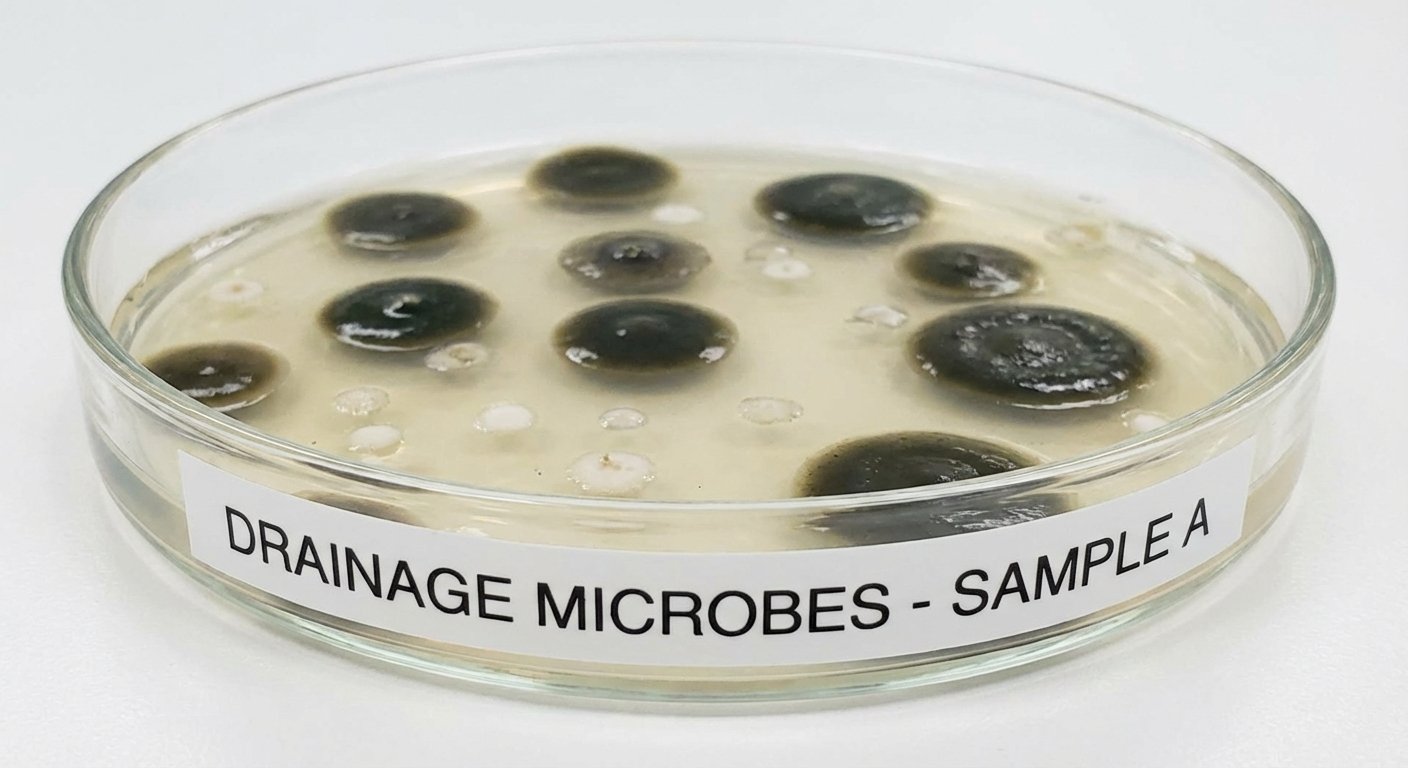
Baktēriju kolonijas petri traukā saistībā ar kanalizācijas tīrīšanu

Baktērijas kanalizācijai palīdz novērst aizsprostojumus
Kā baktērijas kanalizācijai palīdz novērst aizsprostojumus un smakas?
Baktērijas kanalizācijai kā tās palīdz novērst aizsprostojumus ir dabisks un efektīvs risinājums, kas aizvieto ķīmiskos līdzekļus un aizsargā cauruļvadus.
Kanalizācijas sistēmu aizsprostojumi ir bieža problēma, kas rada nepatīkamas smakas un samazina ūdens aizplūdi. Bioloģisko baktēriju izmantošana ir drošs veids, kā uzturēt caurules tīras un izvairīties no bojājumiem.
Šajā rakstā aplūkosim, kas ir bioloģiskie kanalizācijas tīrīšanas līdzekļi, kā baktērijas darbojas cauruļvadu sistēmā un kādas priekšrocības tās sniedz aizsprostojumu novēršanā.
Kas ir bioloģiskie kanalizācijas tīrīšanas līdzekļi?
Bioloģiskie līdzekļi satur aktīvas baktērijas, kas dzīvo dabiski vai tiek audzētas laboratorijā. Šīs baktērijas spēj sadalīt organiskos atkritumus un novērst aizsprostojumus kanalizācijā, neradot kaitējumu videi vai caurulēm.
- Dabiskās un laboratorijā audzētās baktērijas darbojas, sadalot organiskās vielas, piemēram, taukus, eļļas un pārtikas atlikumus.
- Atšķirībā no ķīmiskajiem līdzekļiem, bioloģiskie produkti nav toksiski un nesabojā cauruļvadus vai vidi.
- Šie līdzekļi ir draudzīgi videi un kalpo kā ilgtspējīgs risinājums kanalizācijas sistēmu uzturēšanai.
- Bioloģiskie tīrīšanas līdzekļi pieejami dažādos veidos, piemēram, šķidruma vai granulu formā, atkarībā no pielietojuma mērķa.


Kā baktērijas darbojas cauruļvadu sistēmā?
Baktērijas sadala organiskos atkritumus caurulēs, novēršot to uzkrāšanos un aizsprostojumus. Tās arī apkaro biofilmu veidošanos un palīdz uzturēt cauruļvadus brīvus no tauku, eļļu un ziepju nogulsnēm.
- Organisko atkritumu sadalīšanas process ietver baktēriju enzīmu darbošanos, šķeļot atlikumus sīkās sastāvdaļās.
- Tauku, eļļu un ziepju nogulšņu likvidēšana preventīvi novērš aizsprostus un nepatīkamas smakas.
- Biofilmas veidošanās novēršana saglabā cauruļu iekšpusi tīru un bez piesārņojumiem.
- Baktērijas darbojas visā kanalizācijas sistēmā, ne tikai redzamajās daļās, tādējādi nodrošinot ilgstošu efektu.

Efektīva aizsprostojumu profilakse
Baktērijas novērš aizsprostojumu rašanos, sadalot organisko vielu uzkrāšanos un saglabājot caurules brīvas ilgu laiku.
- Regulāra baktēriju lietošana samazina lielu problēmu riskus.
- Profilakse aiztaupa remontu un dārgas cauruļu nomaiņas izmaksas.

Nepatīkamu smaku likvidēšana
Baktērijas ne tikai attīra kanalizāciju, bet arī likvidē nepatīkamas smakas, kas rodas no pūšanas procesiem un aizsprostojumiem.
- Dabiskā baktēriju iedarbība dezodorē caurules un apkārtējo vidi.
- Smaku novēršana uzlabo dzīves kvalitāti mājās un darba vietās.
Galvenie ieguvumi izmantojot baktērijas aizsprostojumu novēršanai
Baktērijas kanalizācijai nodrošina vairākas būtiskas priekšrocības, kas padara tās par vērtīgu izvēli kanalizācijas sistēmu uzturēšanā.
- Efektīva aizsprostojumu profilakse palīdz samazināt bojājumus un uztur caurules tīras.
- Nepatīkamu smaku likvidēšana uzlabo vidi un novērš dīvainas smakas mājās.
- Cauruļvadu kalpošanas laika pagarināšana ietaupa remontu un ieguldījumus jaunās sistēmās.
- Ekoloģiski drošs risinājums, kas nerada risku cilvēkiem vai videi.

Kā pareizi izvēlēties un lietot baktērijas kanalizācijai?
Izvēloties baktēriju produktus, jāņem vērā to veids un pareiza lietošanas kārtība, lai nodrošinātu maksimālu efektivitāti.
- Dažādi produktu veidi: šķidrumi, granulās vai tabletes dažādiem pielietojumiem un kanalizācijas sistēmām.
- Lietošanas biežums un devas jāievēro, lai baktērijas attīstītos un strādātu vislabāk.
- Svarīgi norādījumi: mitrums, temperatūra un cauruļu stāvoklis ietekmē baktēriju darbību.
- Pilna informācija un produkti pieejami šeit.
Vai baktērijas ir drošas septiskām sistēmām un videi?
Izmantojot dabiskas un bioloģiskas baktērijas, tās ir pilnīgi drošas septiskajām sistēmām un neaizsprosto vidi. Šīs baktērijas veicina ne tikai tīrību, bet arī dabisku noārdīšanos bez kaitējuma videi.
Bioloģiskie līdzekļi nesatur toksiskas vielas, tāpēc ir piemēroti lietošanai gan mājsaimniecībās, gan komerciālajās kanalizācijās. Plašāka informācija par notekūdeņiem pieejama Wikipedia.
Biežāk pieļautās kļūdas, lietojot bioloģiskos līdzekļus
Lai gan baktērijas ir efektīvas, bieži sastopamas kļūdas samazina to iedarbību un var novest pie problēmām kanalizācijā.
- Nepareiza devu lietošana vai retums, kas neļauj baktērijām attīstīties pietiekami pilnā apmērā.
- Izmantojot ķīmiskus līdzekļus kopā ar baktērijām, kas tos iznīcina un samazina mikroorganismu dzīvotspēju.
- Nepareizi glabāšanas apstākļi, kas samazina baktēriju efektivitāti.
- Neievērošana instrukcijām par kanalizācijas sistēmas temperatūru un mitrumu.
Ja jums nepieciešama konsultācija vai atbalsts pareizai baktēriju līdzekļu izvēlei, sazinieties ar speciālistiem šeit.
Kopsavilkums par baktēriju lietošanu kanalizācijā
Baktērijas kanalizācijai ir dabīgs, efektīvs un drošs veids, kā novērst aizsprostojumus un nepatīkamas smakas, vienlaikus pagarinot cauruļu kalpošanas laiku. Pareiza produktu izvēle un lietošana nodrošina ilgtspējīgu kanalizācijas sistēmas uzturēšanu bez ķīmisko līdzekļu kaitējuma.
Izmēģiniet bioloģiskos līdzekļus un uzturiet savu kanalizāciju tīru, drošu un bez aizsprostojumiem!


